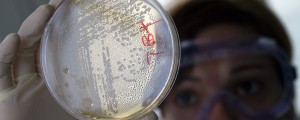

Bakterija E. coli se nahaja v prebavnem traktu ljudi in živali. Večina sevov je neškodljiva za svoje gostitelje. Nekateri sevi imajo virulentne dejavnike in povzročajo črevesne okužbe. Bakterija se prenaša fekalno-oralno preko blata bolnika ali zdravega klicenosca z rokami ali preko okužene hrane in vode.
Bolečine
O tem, kakšni so znaki bolezni, kako se bolezen prenaša in kako se ustrezno zaščitimo, smo se pogovarjali z doc. dr. Ireno Grmek Košnik, dr. med., spec. klin. mikrobiol., spec. javnega zdravja.
»Vir okužbe je človek, ki je lahko bolan ali na videz zdrava oseba – klicenosec. Prenos bakterij iz črevesja okužene osebe v prebavila zdrave osebe je mogoč neposredno preko onesnaženih rok in posredno predvsem z okuženo hrano ali vodo, v katero so prodrle fekalije. Kjer je odstranjevanje teh neustrezno, je verjetno mogoč prenos tudi preko muh, ki prenašajo bakterije na različne površine. Bolezen je lahko zelo nalezljiva, saj je za okužbo z nekaterimi sevi bakterij potrebnih zelo malo bakterij,« pojasnjuje Grmek Košnikova.
Okužbo lahko preprečimo z ustrezno osebno higieno, s temeljitim umivanjem rok po uporabi stranišča, z zagotavljanjem varne pitne vode in s toplotno obdelavo hitro pokvarljivih živil, svetuje dr. Košnikova.
Inkubacija (čas od okužbe do izbruha bolezni) je odvisna od seva bakterije. Traja lahko od 10 ur do osem dni. Bolezenski znaki so krčevite bolečine v trebuhu, vodena ali krvava driska, ki jih lahko spremlja povišana telesna temperatura. Bolezen traja nekaj dni. »Pri okužbi z nekaterimi sevi E. coli lahko pride do nevarnih zapletov, na primer hemolitično uremičnega sindroma (HUS), ki privede do začasne odpovedi ledvic in slabokrvnosti.«
Prenos bakterije
Prisotnost bakterije pri človeku se ugotavlja z laboratorijskim pregledom blata. Tudi po tem, ko je človek bolezen že prebolel, se bakterija še vedno nekaj časa izloča preko blata. »Čeprav je prebolevnik na videz zdrav, ostaja ves ta čas klicenosec, kar pomeni, da lahko okuži druge ljudi neposredno preko ne dovolj dobro umitih rok ali pa posredno, če z ne dovolj umitimi rokami pripravlja hrano oziroma okuži predmete, preko katerih lahko bakterije pridejo v usta druge osebe,« še pojasnjuje Grmek Košnikova.
Najpogosteje pa se z nevarnim sevom bakterije E. coli okužimo z uživanjem surovega govejega mesa (biftek), surovega sadja ali zelenjave, ki je nismo dovolj očistili, bakterija lahko zaide tudi v vodo, ki jo pijemo, dobimo jo lahko preko nepasteriziranega mleka, pa tudi preko hrane, ki jo jemo v restavracijah, če si osebje po uporabi sanitarij ne umije dobro rok. Prav tako se lahko okužimo preko rokovanja in prijemanja predmetov, ki jih uporablja veliko ljudi (kljuka, telefon, računalniška tipkovnica …).
Pri otrocih bolezen lahko privede do hujših zapletov, zato "tečnarimo" toliko časa, da bo temeljito umivanje rok postalo njihova navada.
Zaščita pred okužbo
Bolezen običajno poteka brez večjih zapletov, bolj pa so izpostavljeni starejši in otroci. Pri njih lahko bolezen privede do hujših zapletov. Prav tako lahko bolezen močneje prizadene ljudi, ki imajo oslabljen imunski sistem. Ti so za bakterijo E. coli veliko bolj dovzetni in bolezen težje prebolevajo, saj se njihov organizem slabše bori proti bakterijam.

Komentarji